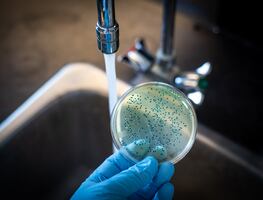
La OMS alerta de un resurgimiento de los casos globales de cólera; ¿Qué es y cómo se contagia?

TE RECOMENDAMOS
El alza de casos de virus sincicial respiratorio (VSR) en niños y adultos mayores en Chile, una de las peores en los últimos años, podría replicarse en México ante la próxima temporada de frío, advirtió a EFE Sarbelio Moreno Espinoza, director de enseñanza y desarrollo académico del Hospital infantil de México "Federico Gómez".
“Lo que ocurre en el Cono Sur es un termómetro para nosotros de qué es lo que va a ocurrir en el hemisferio norte", indicó el experto este lunes en una entrevista con EFE.
"Siempre tener recursos de salud limitados nos puede afectar, pero sí estamos conscientes de que viene duro”, dijo.
El alza en casos de VSR en junio y julio entre niños y adultos mayores generó una alerta sanitaria en Chile por la alta ocupación hospitalaria que no había ocurrido en años recientes.
El especialista aseguró que esta enfermedad es peligrosa porque afecta a dos grupos vulnerables: adultos mayores y recién nacidos, principalmente a los prematuros y aquellos con problemas pulmonares o del corazón desde el alumbramiento.
“La desventaja es que los niños se pueden enfermar desde el nacimiento, sobre todo si nacen en la época de otoño o invierno, por eso la estrategia es vacunar a la madre aún embarazada para que los niños tengan anticuerpos al nacer”, explicó.
¿Existen vacunas contra el virus sincicial respiratorio?
Existen dos vacunas aprobadas hace unas semanas para prevenir este virus con una eficacia de cerca de 60%, una de ellas para personas de la tercera edad y la otra, a las madres gestantes.
En México, desde hace 25 años se usan los anticuerpos monoclonales contra el virus, un método que no induce la formación de anticuerpos como la vacuna, sino que es una inmunidad pasiva.
Hasta hace unos meses era aplicada cada mes a los lactantes en riesgo, ahora puede ser dosificada una sola vez a bebés de hasta ocho meses tengan o no factores de riesgo.
Ante el incremento de casos de covid-19 en México en semanas recientes, Moreno Espinoza consideró que pese a que este tipo de virus no afecta tanto a la niñez, sí puede ser un factor agravante del virus sincicial.
“El SARS-CoV-2 no causa una enfermedad tan grave en los niños pequeñitos, se antoja que si al niño le da infección sincicial respiratoria al mismo tiempo, sí la puede pasar más mal, pero es algo que pocas veces ocurre”, indicó.
El especialista llamó a la población a no dejar el uso de cubrebocas en espacios cerrados o muy concurridos y evitar el contacto de niños enfermos con otros menores de edad o con personas de la tercera edad, para evitar un mayor número de contagios.
VSR: ¿Qué es y por qué deberíamos preocuparnos?
El Virus Sincicial Respiratorio es un patógeno que afecta principalmente a los pulmones y las vías respiratorias, causando síntomas similares a los de un resfriado común o una gripe, pero que pueden ser mucho más graves en bebés, niños pequeños y adultos mayores. Si bien la mayoría de las personas se recupera de una infección por VSR sin problemas, para ciertos grupos de riesgo, como los mencionados anteriormente, puede ser mortal.
Síntomas Clave del VSR en el Turismo
Los síntomas del VSR incluyen fiebre, tos, secreción nasal, dificultad para respirar y sibilancias. Estos síntomas pueden ser confundidos fácilmente con los del COVID-19, lo que genera preocupación adicional en el mundo de los viajes, donde la detección temprana y el aislamiento son esenciales para prevenir la propagación de enfermedades.
Contagio del VSR: Un Desafío en el Turismo
El VSR se propaga principalmente a través de gotitas respiratorias cuando una persona infectada tose o estornuda. También puede transmitirse tocando superficies contaminadas y luego tocando los ojos, la nariz o la boca. Esto plantea un desafío adicional en el turismo, donde la interacción cercana entre personas y la exposición a superficies compartidas son comunes.
Medidas de Prevención en el Turismo
Para garantizar la seguridad de los viajeros, las empresas de la industria turística deben tomar medidas proactivas. Esto incluye la implementación de protocolos de limpieza y desinfección rigurosos, promoción del distanciamiento social, y el uso generalizado de mascarillas y desinfectantes de manos. Además, la educación sobre los síntomas del VSR y las medidas preventivas deben ser una parte integral de la experiencia de viaje.
[Publicidad]